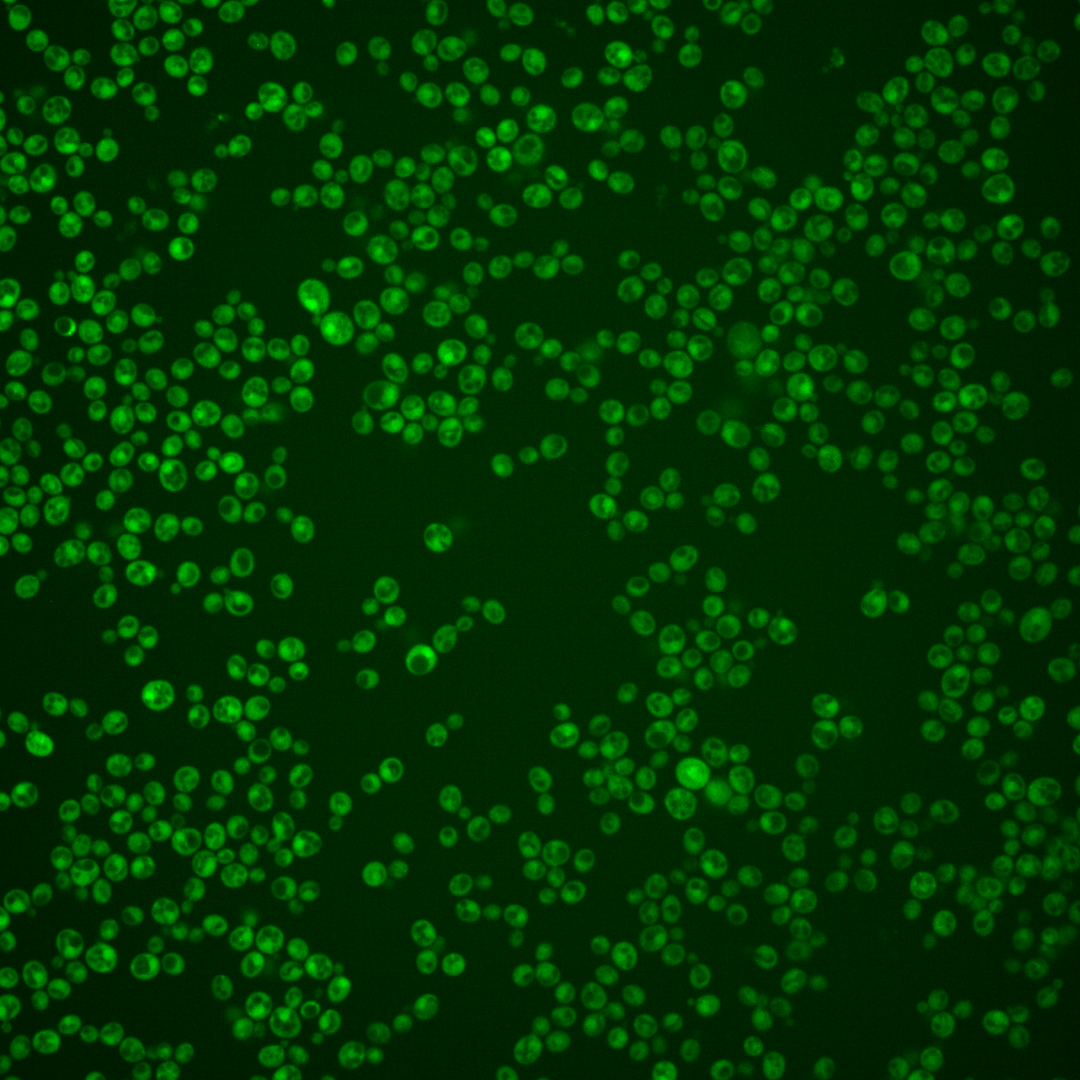
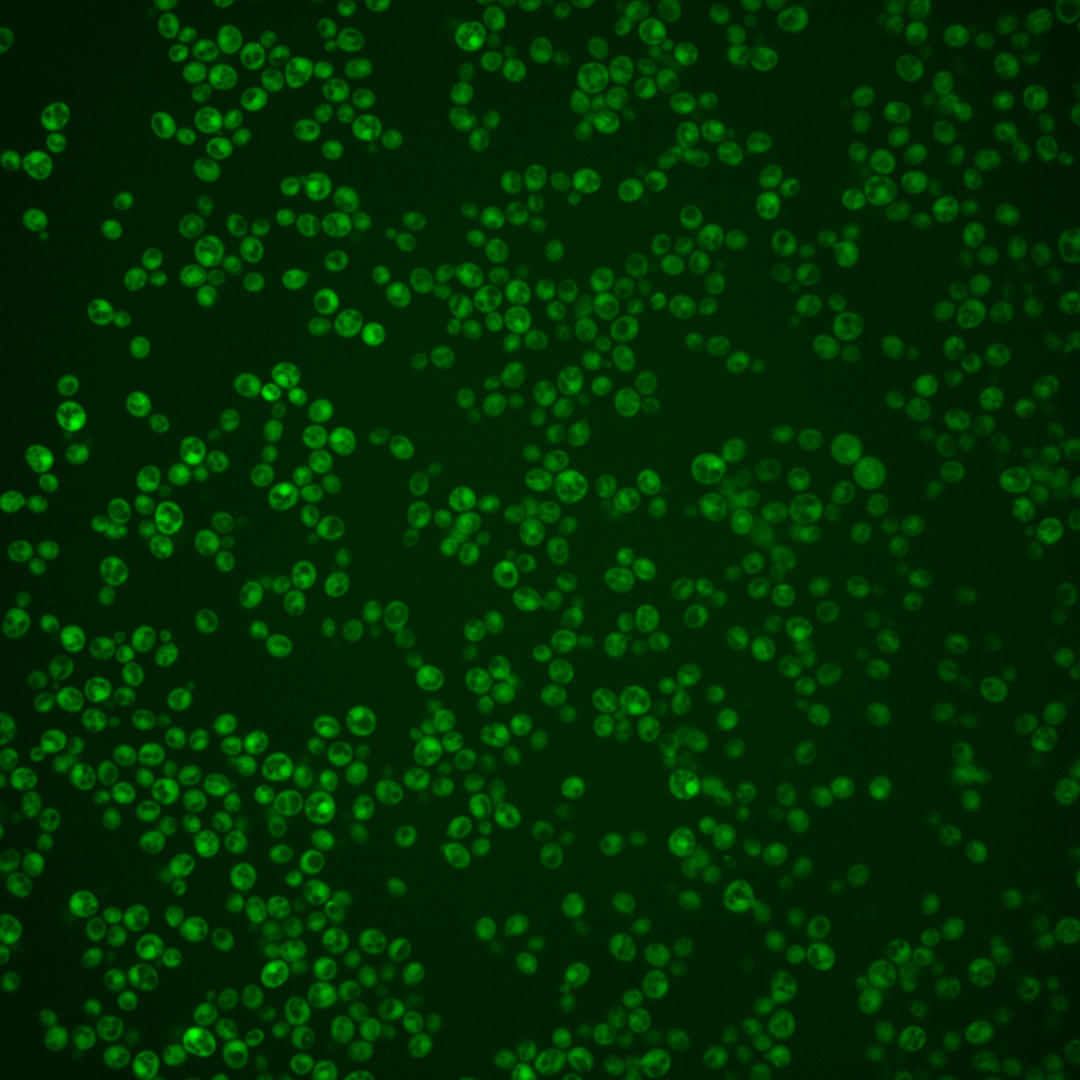

| ORF | |
|---|---|
| Human Ortholog | |
| Description | Dubious open reading frame; unlikely to encode a functional protein, based on available experimental and comparative sequence data; partially overlaps the verified gene MRPL38 |
Micrographs




















































































Sub-cellular Localization
Yeast GFP Assignment
Protein Abundance
Localization Change
External localization resources
| ensLOC | DeepLoc | |||||||||||||||||||||||
|---|---|---|---|---|---|---|---|---|---|---|---|---|---|---|---|---|---|---|---|---|---|---|---|---|
| Localization | WT1 | WT2 | WT3 | RAP60 | RAP140 | RAP220 | RAP300 | RAP380 | RAP460 | RAP540 | RAP620 | RAP700 | HU80 | HU120 | HU160 | rpd3Δ_1 | rpd3Δ_2 | rpd3Δ_3 | WT1 | WT2 | WT3 | AF100 | AF140 | AF180 |
| Cortical Patches | 0 | 0 | 0 | 0 | 0 | 0 | – | 0 | 0 | 0 | 1 | 1 | 0 | 0 | 0 | 0 | 0 | 1 | 0 | 0 | 0 | 0 | 2 | 7 |
| Bud | 0 | 0 | 2 | 4 | 3 | 4 | – | 7 | 7 | 8 | 4 | 6 | 2 | 1 | 2 | 0 | 0 | 0 | 5 | 3 | 1 | 4 | 21 | 42 |
| Bud Neck | 0 | 0 | 0 | 0 | 0 | 0 | – | 2 | 0 | 3 | 0 | 0 | 0 | 0 | 0 | 0 | 0 | 0 | 2 | 0 | 0 | 0 | 1 | 4 |
| Bud Site | 0 | 0 | 0 | 0 | 0 | 0 | – | 1 | 0 | 0 | 0 | 1 | 0 | 0 | 0 | 0 | 0 | 0 | – | – | – | – | – | – |
| Cell Periphery | 1 | 0 | 0 | 0 | 0 | 1 | – | 2 | 1 | 2 | 4 | 2 | 0 | 0 | 1 | 1 | 0 | 0 | 0 | 0 | 0 | 0 | 0 | 0 |
| Cytoplasm | 227 | 46 | 13 | 120 | 215 | 192 | – | 406 | 183 | 200 | 112 | 162 | 261 | 429 | 519 | 53 | 39 | 47 | 210 | 76 | 46 | 79 | 282 | 241 |
| Endoplasmic Reticulum | 2 | 0 | 0 | 0 | 2 | 0 | – | 0 | 0 | 1 | 0 | 3 | 1 | 1 | 1 | 1 | 1 | 4 | 0 | 0 | 0 | 0 | 1 | 3 |
| Endosome | 2 | 1 | 0 | 1 | 3 | 1 | – | 2 | 0 | 2 | 1 | 1 | 8 | 5 | 4 | 6 | 3 | 7 | 6 | 1 | 1 | 0 | 8 | 29 |
| Golgi | 1 | 0 | 0 | 1 | 0 | 0 | – | 0 | 0 | 1 | 0 | 0 | 1 | 0 | 0 | 3 | 2 | 6 | 3 | 0 | 0 | 0 | 2 | 22 |
| Mitochondria | 7 | 2 | 3 | 26 | 17 | 77 | – | 213 | 163 | 176 | 90 | 148 | 4 | 12 | 6 | 4 | 4 | 4 | 8 | 1 | 2 | 0 | 3 | 11 |
| Nucleus | 3 | 0 | 1 | 0 | 1 | 0 | – | 6 | 0 | 8 | 3 | 3 | 3 | 0 | 1 | 1 | 0 | 0 | 18 | 5 | 1 | 6 | 13 | 17 |
| Nuclear Periphery | 0 | 0 | 0 | 1 | 0 | 0 | – | 3 | 1 | 1 | 0 | 2 | 0 | 0 | 0 | 0 | 0 | 0 | 1 | 0 | 0 | 0 | 0 | 1 |
| Nucleolus | 1 | 1 | 0 | 0 | 0 | 0 | – | 2 | 0 | 2 | 1 | 0 | 2 | 5 | 1 | 12 | 3 | 8 | 0 | 0 | 0 | 1 | 1 | 1 |
| Peroxisomes | 0 | 0 | 0 | 0 | 0 | 0 | – | 0 | 0 | 0 | 0 | 0 | 0 | 3 | 1 | 1 | 1 | 0 | 0 | 1 | 0 | 0 | 0 | 5 |
| SpindlePole | 0 | 0 | 0 | 0 | 0 | 0 | – | 5 | 2 | 1 | 1 | 2 | 1 | 1 | 1 | 1 | 0 | 1 | 3 | 1 | 1 | 6 | 10 | 30 |
| Vac/Vac Membrane | 32 | 10 | 0 | 17 | 23 | 2 | – | 16 | 3 | 5 | 7 | 3 | 75 | 37 | 15 | 29 | 22 | 27 | 5 | 2 | 2 | 4 | 13 | 19 |
| Unique Cell Count | 260 | 58 | 17 | 152 | 248 | 231 | 521 | 272 | 319 | 174 | 256 | 332 | 474 | 538 | 95 | 68 | 90 | 268 | 96 | 61 | 103 | 369 | 444 | |
| Labelled Cell Count | 276 | 60 | 19 | 170 | 264 | 277 | 665 | 360 | 410 | 224 | 334 | 358 | 494 | 552 | 112 | 75 | 105 | 268 | 96 | 61 | 103 | 369 | 444 | |
Yeast GFP Assignment
Protein Abundance
| Screen | WT1 | WT2 | WT3 | RAP60 | RAP140 | RAP220 | RAP300 | RAP380 | RAP460 | RAP540 | RAP620 | RAP700 | HU80 | HU120 | HU160 | rpd3Δ_1 | rpd3Δ_2 | rpd3Δ_3 | AF100 | AF140 | AF180 |
|---|---|---|---|---|---|---|---|---|---|---|---|---|---|---|---|---|---|---|---|---|---|
| Mean Cell GFP Intensity (1e-4) | 7.2 | 6.8 | 4.9 | 6.1 | 5.7 | 3.5 | – | 3.5 | 3.0 | 3.5 | 3.2 | 3.6 | 10.6 | 9.1 | 6.6 | 18.9 | 16.6 | 17.7 | 7.2 | 7.2 | 7.5 |
| Std Deviation (1e-4) | 1.7 | 2.0 | 1.5 | 3.3 | 1.8 | 1.2 | – | 1.4 | 1.3 | 1.8 | 1.6 | 8.6 | 3.6 | 3.9 | 1.8 | 13.9 | 7.5 | 9.2 | 3.4 | 2.2 | 2.3 |
| Intensity Change (Log2) | – | – | – | 0.32 | 0.22 | -0.47 | – | -0.48 | -0.72 | -0.48 | -0.59 | -0.44 | 1.11 | 0.9 | 0.44 | 1.96 | 1.77 | 1.86 | 0.56 | 0.55 | 0.62 |
Localization Change
| Localization | RAP60 | RAP140 | RAP220 | RAP300 | RAP380 | RAP460 | RAP540 | RAP620 | RAP700 | HU80 | HU120 | HU160 | rpd3Δ_1 | rpd3Δ_2 | rpd3Δ_3 |
|---|---|---|---|---|---|---|---|---|---|---|---|---|---|---|---|
| Cortical Patches | 0 | 0 | 0 | – | 0 | 0 | 0 | 0 | 0 | 0 | 0 | 0 | 0 | 0 | 0 |
| Bud | 0 | 0 | 0 | – | 0 | 0 | 0 | 0 | 0 | 0 | 0 | 0 | 0 | 0 | 0 |
| Bud Neck | 0 | 0 | 0 | – | 0 | 0 | 0 | 0 | 0 | 0 | 0 | 0 | 0 | 0 | 0 |
| Bud Site | 0 | 0 | 0 | – | 0 | 0 | 0 | 0 | 0 | 0 | 0 | 0 | 0 | 0 | 0 |
| Cell Periphery | 0 | 0 | 0 | – | 0 | 0 | 0 | 0 | 0 | 0 | 0 | 0 | 0 | 0 | 0 |
| Cytoplasm | 0.2 | 1.2 | 0.7 | – | 0.1 | -0.8 | -1.1 | -1.0 | -1.1 | 0.2 | 1.9 | 4.1 | -1.6 | -1.4 | -1.8 |
| Endoplasmic Reticulum | 0 | 0 | 0 | – | 0 | 0 | 0 | 0 | 0 | 0 | 0 | 0 | 0 | 0 | 0 |
| Endosome | 0 | 0 | 0 | – | 0 | 0 | 0 | 0 | 0 | 0 | 0 | 0 | 0 | 0 | 0 |
| Golgi | 0 | 0 | 0 | – | 0 | 0 | 0 | 0 | 0 | 0 | 0 | 0 | 0 | 0 | 0 |
| Mitochondria | 0 | 0 | 0 | – | 0 | 0 | 0 | 0 | 0 | 0 | 0 | 0 | 0 | 0 | 0 |
| Nucleus | 0 | 0 | 0 | – | 0 | 0 | 0 | 0 | 0 | 0 | 0 | 0 | 0 | 0 | 0 |
| Nuclear Periphery | 0 | 0 | 0 | – | 0 | 0 | 0 | 0 | 0 | 0 | 0 | 0 | 0 | 0 | 0 |
| Nucleolus | 0 | 0 | 0 | – | 0 | 0 | 0 | 0 | 0 | 0 | 0 | 0 | 0 | 0 | 0 |
| Peroxisomes | 0 | 0 | 0 | – | 0 | 0 | 0 | 0 | 0 | 0 | 0 | 0 | 0 | 0 | 0 |
| SpindlePole | 0 | 0 | 0 | – | 0 | 0 | 0 | 0 | 0 | 0 | 0 | 0 | 0 | 0 | 0 |
| Vacuole | 0 | 0 | 0 | – | 0 | 0 | 0 | 0 | 0 | 0 | 0 | 0 | 0 | 0 | 0 |
External localization resources
Images






























Protein Concentration and Protein Localization Data
| R1 | R2 | R3 | ||||||||||||||||
|---|---|---|---|---|---|---|---|---|---|---|---|---|---|---|---|---|---|---|
| G1 Pre-START | G1 Post-START | S/G2 | Metaphase | Anaphase | Telophase | G1 Pre-START | G1 Post-START | S/G2 | Metaphase | Anaphase | Telophase | G1 Pre-START | G1 Post-START | S/G2 | Metaphase | Anaphase | Telophase | |
| Concentration | 3.9248 | 7.4421 | 6.3978 | 5.7154 | 5.1401 | 6.6306 | 5.196 | 9.7457 | 7.5961 | 6.5702 | 7.8193 | 7.5345 | 7.3681 | 10.7155 | 9.8428 | 8.428 | 8.9045 | 9.0336 |
| Actin | 0.0308 | 0.0026 | 0.0264 | 0.0573 | 0.0059 | 0.0072 | 0.037 | 0.0004 | 0.0088 | 0.0176 | 0.0069 | 0.0021 | 0.0622 | 0.0005 | 0.003 | 0.0084 | 0.0163 | 0.0024 |
| Bud | 0.001 | 0.0009 | 0.0016 | 0.0011 | 0.0008 | 0.0004 | 0.0016 | 0.0003 | 0.0006 | 0.0005 | 0.0018 | 0.0003 | 0.0006 | 0.0002 | 0.0003 | 0.0022 | 0.0004 | 0.0003 |
| Bud Neck | 0.0054 | 0.0005 | 0.0018 | 0.0097 | 0.0012 | 0.0017 | 0.0075 | 0.0004 | 0.0016 | 0.0252 | 0.0018 | 0.0023 | 0.0033 | 0.0003 | 0.0008 | 0.0127 | 0.001 | 0.0017 |
| Bud Periphery | 0.0006 | 0.0004 | 0.0009 | 0.0029 | 0.001 | 0.0005 | 0.0014 | 0.0002 | 0.0006 | 0.0003 | 0.0005 | 0.0002 | 0.0004 | 0 | 0.0001 | 0.0032 | 0.0006 | 0.0002 |
| Bud Site | 0.0065 | 0.0014 | 0.0022 | 0.0025 | 0.0038 | 0.0004 | 0.0075 | 0.0005 | 0.0018 | 0.0009 | 0.0008 | 0.0005 | 0.0008 | 0.0004 | 0.0037 | 0.003 | 0.0006 | 0.0002 |
| Cell Periphery | 0.0004 | 0.0001 | 0.0001 | 0.0017 | 0.0001 | 0 | 0.001 | 0 | 0.0001 | 0.0001 | 0.0001 | 0 | 0.0001 | 0 | 0.0001 | 0.0003 | 0.0002 | 0 |
| Cytoplasm | 0.6952 | 0.844 | 0.6719 | 0.6221 | 0.6868 | 0.6947 | 0.6143 | 0.7499 | 0.6688 | 0.6007 | 0.6543 | 0.6269 | 0.6828 | 0.8004 | 0.7385 | 0.6927 | 0.7231 | 0.7022 |
| Cytoplasmic Foci | 0.0378 | 0.0036 | 0.0169 | 0.0166 | 0.0178 | 0.019 | 0.0381 | 0.0123 | 0.0271 | 0.0163 | 0.0539 | 0.0148 | 0.0077 | 0.0022 | 0.0054 | 0.0022 | 0.0038 | 0.0032 |
| Eisosomes | 0.0003 | 0.0001 | 0.0001 | 0.0005 | 0.0001 | 0.0001 | 0.0007 | 0 | 0 | 0.0001 | 0 | 0 | 0.0003 | 0 | 0.0002 | 0 | 0.0004 | 0 |
| Endoplasmic Reticulum | 0.0143 | 0.0029 | 0.0057 | 0.0043 | 0.0039 | 0.0054 | 0.0122 | 0.0026 | 0.0046 | 0.0042 | 0.0058 | 0.0035 | 0.0116 | 0.0024 | 0.0027 | 0.0023 | 0.0142 | 0.003 |
| Endosome | 0.0539 | 0.0034 | 0.0273 | 0.0177 | 0.0349 | 0.0172 | 0.0539 | 0.0034 | 0.0227 | 0.0332 | 0.0295 | 0.0149 | 0.0187 | 0.0011 | 0.0025 | 0.004 | 0.0109 | 0.0044 |
| Golgi | 0.0083 | 0.0006 | 0.0154 | 0.0212 | 0.011 | 0.0047 | 0.01 | 0.0004 | 0.0069 | 0.0221 | 0.002 | 0.0033 | 0.0042 | 0.0001 | 0.0003 | 0.0018 | 0.0024 | 0.0048 |
| Lipid Particles | 0.0107 | 0.0002 | 0.0086 | 0.0087 | 0.0071 | 0.0051 | 0.0094 | 0.0002 | 0.007 | 0.0108 | 0.0034 | 0.0024 | 0.003 | 0 | 0.001 | 0.0003 | 0.0012 | 0.0044 |
| Mitochondria | 0.0023 | 0.0089 | 0.0074 | 0.0195 | 0.0551 | 0.0128 | 0.0074 | 0.0063 | 0.0092 | 0.0111 | 0.0017 | 0.0074 | 0.0021 | 0.0002 | 0.0013 | 0.0011 | 0.0083 | 0.0067 |
| None | 0.0329 | 0.0038 | 0.0082 | 0.0088 | 0.0093 | 0.0049 | 0.0184 | 0.0114 | 0.003 | 0.0026 | 0.0068 | 0.002 | 0.0339 | 0.0023 | 0.0111 | 0.0013 | 0.0034 | 0.0017 |
| Nuclear Periphery | 0.0202 | 0.008 | 0.0142 | 0.0104 | 0.0129 | 0.0174 | 0.0321 | 0.0129 | 0.0154 | 0.0153 | 0.0196 | 0.0175 | 0.0247 | 0.0095 | 0.0101 | 0.0117 | 0.0229 | 0.0153 |
| Nucleolus | 0.0007 | 0.0001 | 0.0006 | 0.0004 | 0.0005 | 0.0005 | 0.0008 | 0.0001 | 0.0004 | 0.0007 | 0.0005 | 0.0002 | 0.0004 | 0.0001 | 0.0004 | 0.0003 | 0.0003 | 0.0004 |
| Nucleus | 0.0574 | 0.113 | 0.1732 | 0.1717 | 0.0856 | 0.1945 | 0.1199 | 0.185 | 0.1995 | 0.2179 | 0.1867 | 0.2907 | 0.1308 | 0.1779 | 0.2029 | 0.2461 | 0.1813 | 0.2406 |
| Peroxisomes | 0.0045 | 0.0002 | 0.006 | 0.0083 | 0.0508 | 0.0024 | 0.007 | 0.0004 | 0.0073 | 0.0128 | 0.0051 | 0.0012 | 0.002 | 0.0001 | 0.0014 | 0.0004 | 0.0003 | 0.0008 |
| Punctate Nuclear | 0.0094 | 0.0035 | 0.0079 | 0.0045 | 0.0069 | 0.0062 | 0.0106 | 0.0118 | 0.0083 | 0.004 | 0.0154 | 0.007 | 0.0065 | 0.0014 | 0.0131 | 0.003 | 0.0047 | 0.0062 |
| Vacuole | 0.006 | 0.0014 | 0.0026 | 0.007 | 0.0029 | 0.0034 | 0.0067 | 0.0011 | 0.0048 | 0.0028 | 0.0026 | 0.0021 | 0.0024 | 0.0008 | 0.0007 | 0.0024 | 0.0021 | 0.001 |
| Vacuole Periphery | 0.0013 | 0.0005 | 0.001 | 0.003 | 0.0014 | 0.0015 | 0.0024 | 0.0003 | 0.0013 | 0.0007 | 0.0008 | 0.0005 | 0.0013 | 0.0002 | 0.0002 | 0.0005 | 0.0017 | 0.0005 |
Sequencing Data
| R1 | R2 | |||||||||
|---|---|---|---|---|---|---|---|---|---|---|
| G1 Post-START | S/G2 | Metaphase | Anaphase | Telophase | G1 Post-START | S/G2 | Metaphase | Anaphase | Telophase | |
| Gene Expression | – | – | – | – | – | – | – | – | – | – |
| Translational Efficiency | – | – | – | – | – | – | – | – | – | – |
Hit Data
| Dataset | Hit |
|---|---|
| Protein Concentration | ✘ |
| Protein Localization | ✘ |
| Gene Expression | – |
| Translational Efficiency | – |
Endocytosis
| Temp | Actin Patch (Sac6-tdTomato) | Cortical Patch (Sla1-GFP) | Late Endosome (Snf7-GFP) | Vacuole (Vph1-GFP) |
|---|---|---|---|---|
| 37℃ | ||||
| RT |
Cell Cycle Omics
CYCLoPs (Ykl169c-GFP)
| Gene / Allele | Actin Patch (Sac6-tdTomato) | Cortical Patch (Sla1-GFP) | Late Endosome (Snf7-GFP) | Vacuole (Sac6-tdTomato) |
|---|
| Gene | Images |
|---|
| Gene | Images |
|---|
Images are not yet available
Images are not yet available